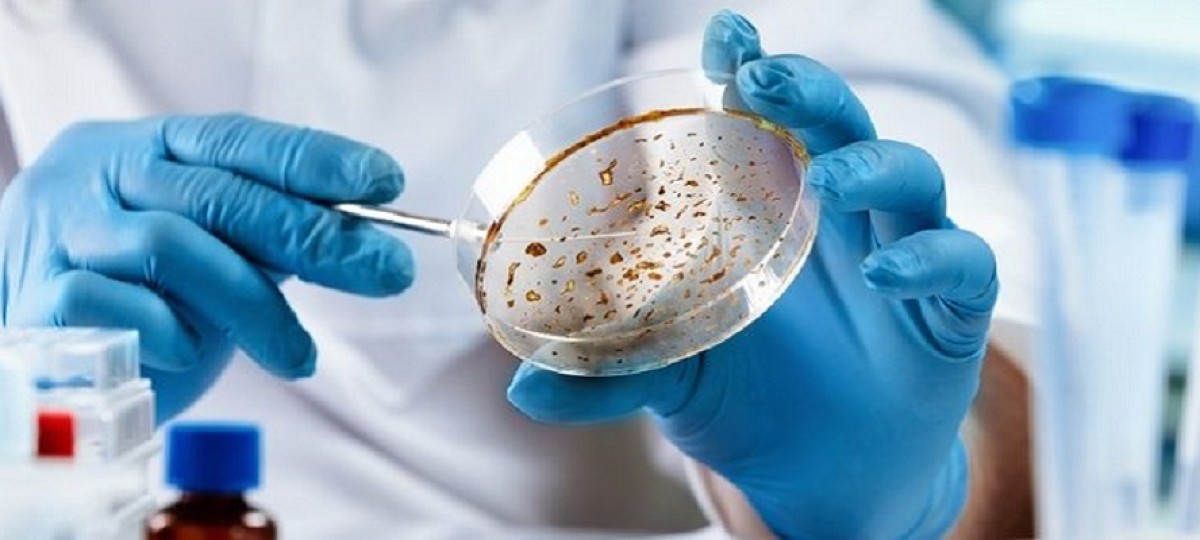
Antibiotici, consumi stagnanti e inappropriati. UE lontana da obiettivi di antibiotico-resistenza

antibioticoresistenza
18 Novembre 2025L’Europa è in ritardo sugli obiettivi 2030 sull’uso degli antibiotici e sulla riduzione della resistenza antimicrobica: i consumi aumentano, la quota di antibiotici di prima linea resta bassa e le infezioni da batteri resistenti continuano a crescere, con oltre 35.000 decessi l’anno nella UE/SEE
I nuovi dati pubblicati dall’Ecdc in occasione dell’European Antibiotic Awareness Day rivelano che in Europa la resistenza antimicrobica (Amr) continua ad aumentare e che nonostante gli sforzi dei Paesi e degli operatori sanitario quattro dei cinque obiettivi Amr fissati dal Consiglio dell’UE per il 2030 sono ancora lontani. E in un mondo orami interconnesso l’Amr complica ulteriormente le sfide sanitarie derivanti dalle malattie non trasmissibili, dai cambiamenti demografici e dalla carenza di forza lavoro sanitaria.
L’Ecdc sottolinea anche l’importanza dei dati di sorveglianza del consumo di antimicrobici per guidare e valutare gli interventi mirati all’Amr è evidenziata sia a livello UE che globale
La Raccomandazione del Consiglio adottata il 13 giugno 2023 ha definito cinque obiettivi relativi al consumo e alla resistenza antimicrobica da raggiungere entro il 2030 da parte dell’UE e dei singoli Stati membri, con il 2019 come anno di riferimento.
Obiettivi dell’UE
Secondo il Report dell’Ecdc, dal 2019, l’incidenza stimata delle sepsi causate da Klebsiella pneumoniae resistente ai carbapenemi è aumentata di oltre il 60%, nonostante un obiettivo di riduzione del 5% entro il 2030. Allo stesso modo, quelle causate da Escherichia coli resistente alle cefalosporine di terza generazione sono aumentate di oltre il 5%, nonostante un obiettivo di riduzione del 10%.
La sorveglianza dell’ECDC mostra inoltre che, nel 2024, la resistenza antimicrobica nell’UE/SEE è rimasta complessivamente su livelli elevati. Oltre ai trend osservati per K. pneumoniae ed E. coli, si registrano incrementi anche per altre combinazioni batterio-antibiotico sotto monitoraggio, tra cui Streptococcus pneumoniae e Enterococcus faecium resistente alla vancomicina.
L’andamento varia significativamente tra i Paesi europei, con una maggiore prevalenza delle resistenze nell’Europa meridionale, centrale e orientale.
Le sepsi sostenute da batteri resistenti continuano a rappresentare un rilevante problema di sanità pubblica, con più di 35.000 decessi annui stimati nell’UE/SEE come conseguenza diretta della resistenza antimicrobica. Le differenze geografiche e la diffusione di microrganismi resistenti ai principali antibiotici ospedalieri, come i carbapenemi, suggeriscono che senza un rafforzamento delle strategie di prevenzione e controllo delle infezioni sarà difficile invertire l’attuale tendenza.
La chiave per dare una risposta efficace all’Amr è garantire un uso prudente degli antimicrobici, ma in contrasto con l’obiettivo di riduzione del 20% il consumo di antibiotici è aumentato anche nel 2024. Il consumo totale medio ponderato per popolazione dell’UE (settori comunitario e ospedaliero combinati) di antibatterici per uso sistemico è stato pari a 20,3 DDD per 1.000 abitanti al giorno. Un valore superiore del 2% rispetto al 2019 (anno di riferimento) e superiore di 4,4 DDD per 1.000 abitanti al giorno rispetto all’obiettivo 2030 di 15,9 DDD per 1.000 abitanti al giorno. I risultati delle analisi sui cinque anni per il periodo 2020−2024 inclusi nel rapporto Ecdc sono influenzati dalla riduzione temporanea dei consumi durante gli anni della pandemia Covid-19 (2020-2021), in particolare il consumo totale e il consumo nella comunità di antibatterici per uso sistemico
Nel 2024 la percentuale media ponderata del consumo di antimicrobici del gruppo “Access” dell’indice AWaRe, cioè quelli consigliati come prima o seconda scelta per le infezioni più comuni, come l'amoxicillina, la cefazolina e il metronidazolo, è rimasta “stagnante” al 60,3% e inferiore dell’1% rispetto al 2019 e del 4,7% rispetto all’obiettivo 2030 (>65%).
Diversi fattori stanno contribuendo all’aumento delle infezioni difficili da trattare: una popolazione che invecchia con malattie croniche sottostanti che la rendono più vulnerabile alle infezioni, la trasmissione transfrontaliera di microrganismi resistenti e l’elevato uso persistente di antibiotici combinato a lacune nella prevenzione e nel controllo delle infezioni.
Allo stesso tempo, la pipeline globale degli antibiotici rimane limitata, soprattutto contro microrganismi critici prioritari per la salute pubblica, come i batteri gram-negativi resistenti ai carbapenemi. Inoltre, i dati evidenziano un uso subottimale degli antibiotici di prima linea del gruppo “Access” e una crescente dipendenza dagli antibiotici di ultima istanza.
Sono necessarie soluzioni innovative per rallentare l’aumento dell’AMR, ma ci sono pochissimi nuovi antibiotici con meccanismi d’azione innovativi vicini all’approvazione. Come ricorda la direttrice dell’ECDC Pamela Rendi-Wagner, “è necessaria un’innovazione su tre fronti fondamentali: una forte azione per un uso responsabile degli antibiotici, pratiche sostenute e standardizzate di prevenzione e controllo delle infezioni e nuovi antibiotici in fase di sviluppo”.
L’Ecdc stima che le infezioni resistenti agli antimicrobici causino ogni anno più di 35.000 decessi nella UE/SEE, oltre a minare la medicina moderna, mettendo a rischio procedure salvavita come i trapianti d’organo, la terapia oncologica, la chirurgia e la terapia intensiva.
L’Ecdc continua a monitorare la resistenza antimicrobica e il consumo di antimicrobici in tutta Europa, valutando i rischi per la salute pubblica e stimando l’impatto delle infezioni resistenti. Il Centro collabora con i Paesi dell’UE/SEE per rafforzare i sistemi di sorveglianza, potenziare le capacità dei laboratori e utilizzare strumenti digitali e cartelle cliniche elettroniche per decisioni sempre più basate sui dati. Importante anche il supporto all’espansione della sorveglianza genomica dei patogeni resistenti, che consente un’identificazione più precoce delle minacce emergenti, un miglior tracciamento dei focolai e una maggiore collaborazione regionale e internazionale. Attraverso valutazioni mirate delle capacità di preparazione e risposta dei singoli Stati, l’Ecdc contribuisce inoltre a garantire che tutti i Paesi dell’UE/SEE siano meglio attrezzati ad affrontare una minaccia complessa e in continua evoluzione come l’antibiotico-resistenza.
Fonte:
Se l'articolo ti è piaciuto rimani in contatto con noi sui nostri canali social seguendoci su:
Oppure rimani sempre aggiornato in ambito farmaceutico iscrivendoti alla nostra newsletter!
POTREBBERO INTERESSARTI ANCHE
11/11/2025
Aifa informa che esiste il rischio di illeggibilità di numero di lotto e data di scadenza sull’etichetta del flaconcino di un anticorpo monoclonale immunoterapico, dopo le procedure di...
A cura di Redazione Farmacista33
05/11/2025
L’Agenzia europea per i medicinali ha lanciato la campagna di sensibilizzazione #ItTakesATeam per mettere in evidenza il lavoro congiunto di regolatori, farmacisti, medici e associazioni di...
A cura di Redazione Farmacista33
03/11/2025
Aifa aderisce alla decima edizione della #MedSafetyWeek, campagna di comunicazione internazionale per un uso più sicuro dei medicinali Dal 3 al 9 novembre focus sulla segnalazione degli effetti...
A cura di Redazione Farmacista33
29/10/2025
Il Consiglio di Amministrazione dell’AIFA – nella seduta del 28 ottobre ha approvato la rimborsabilità per 2 nuove molecole, 1 estensione di indicazione terapeutica, 1 medicinale di importazione...
A cura di Redazione Farmacista33

©2025 Edra S.p.a | www.edraspa.it | P.iva 08056040960 | Tel. 02/881841 | Sede legale: Via Spadolini, 7 - 20141 Milano (Italy)